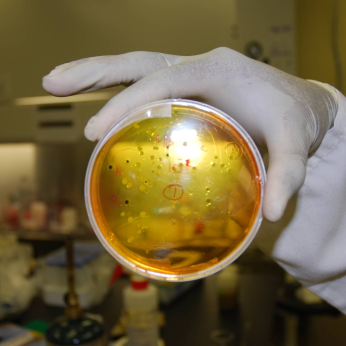

SOILS AT GUELPH
Silver Sponsor
Information
We're advancing sustainable soil management in Ontario by making research accessible and facilitating knowledge sharing between researchers, farmers, industry, government, and the general public.
Product Categories
Ag Services
Learn More